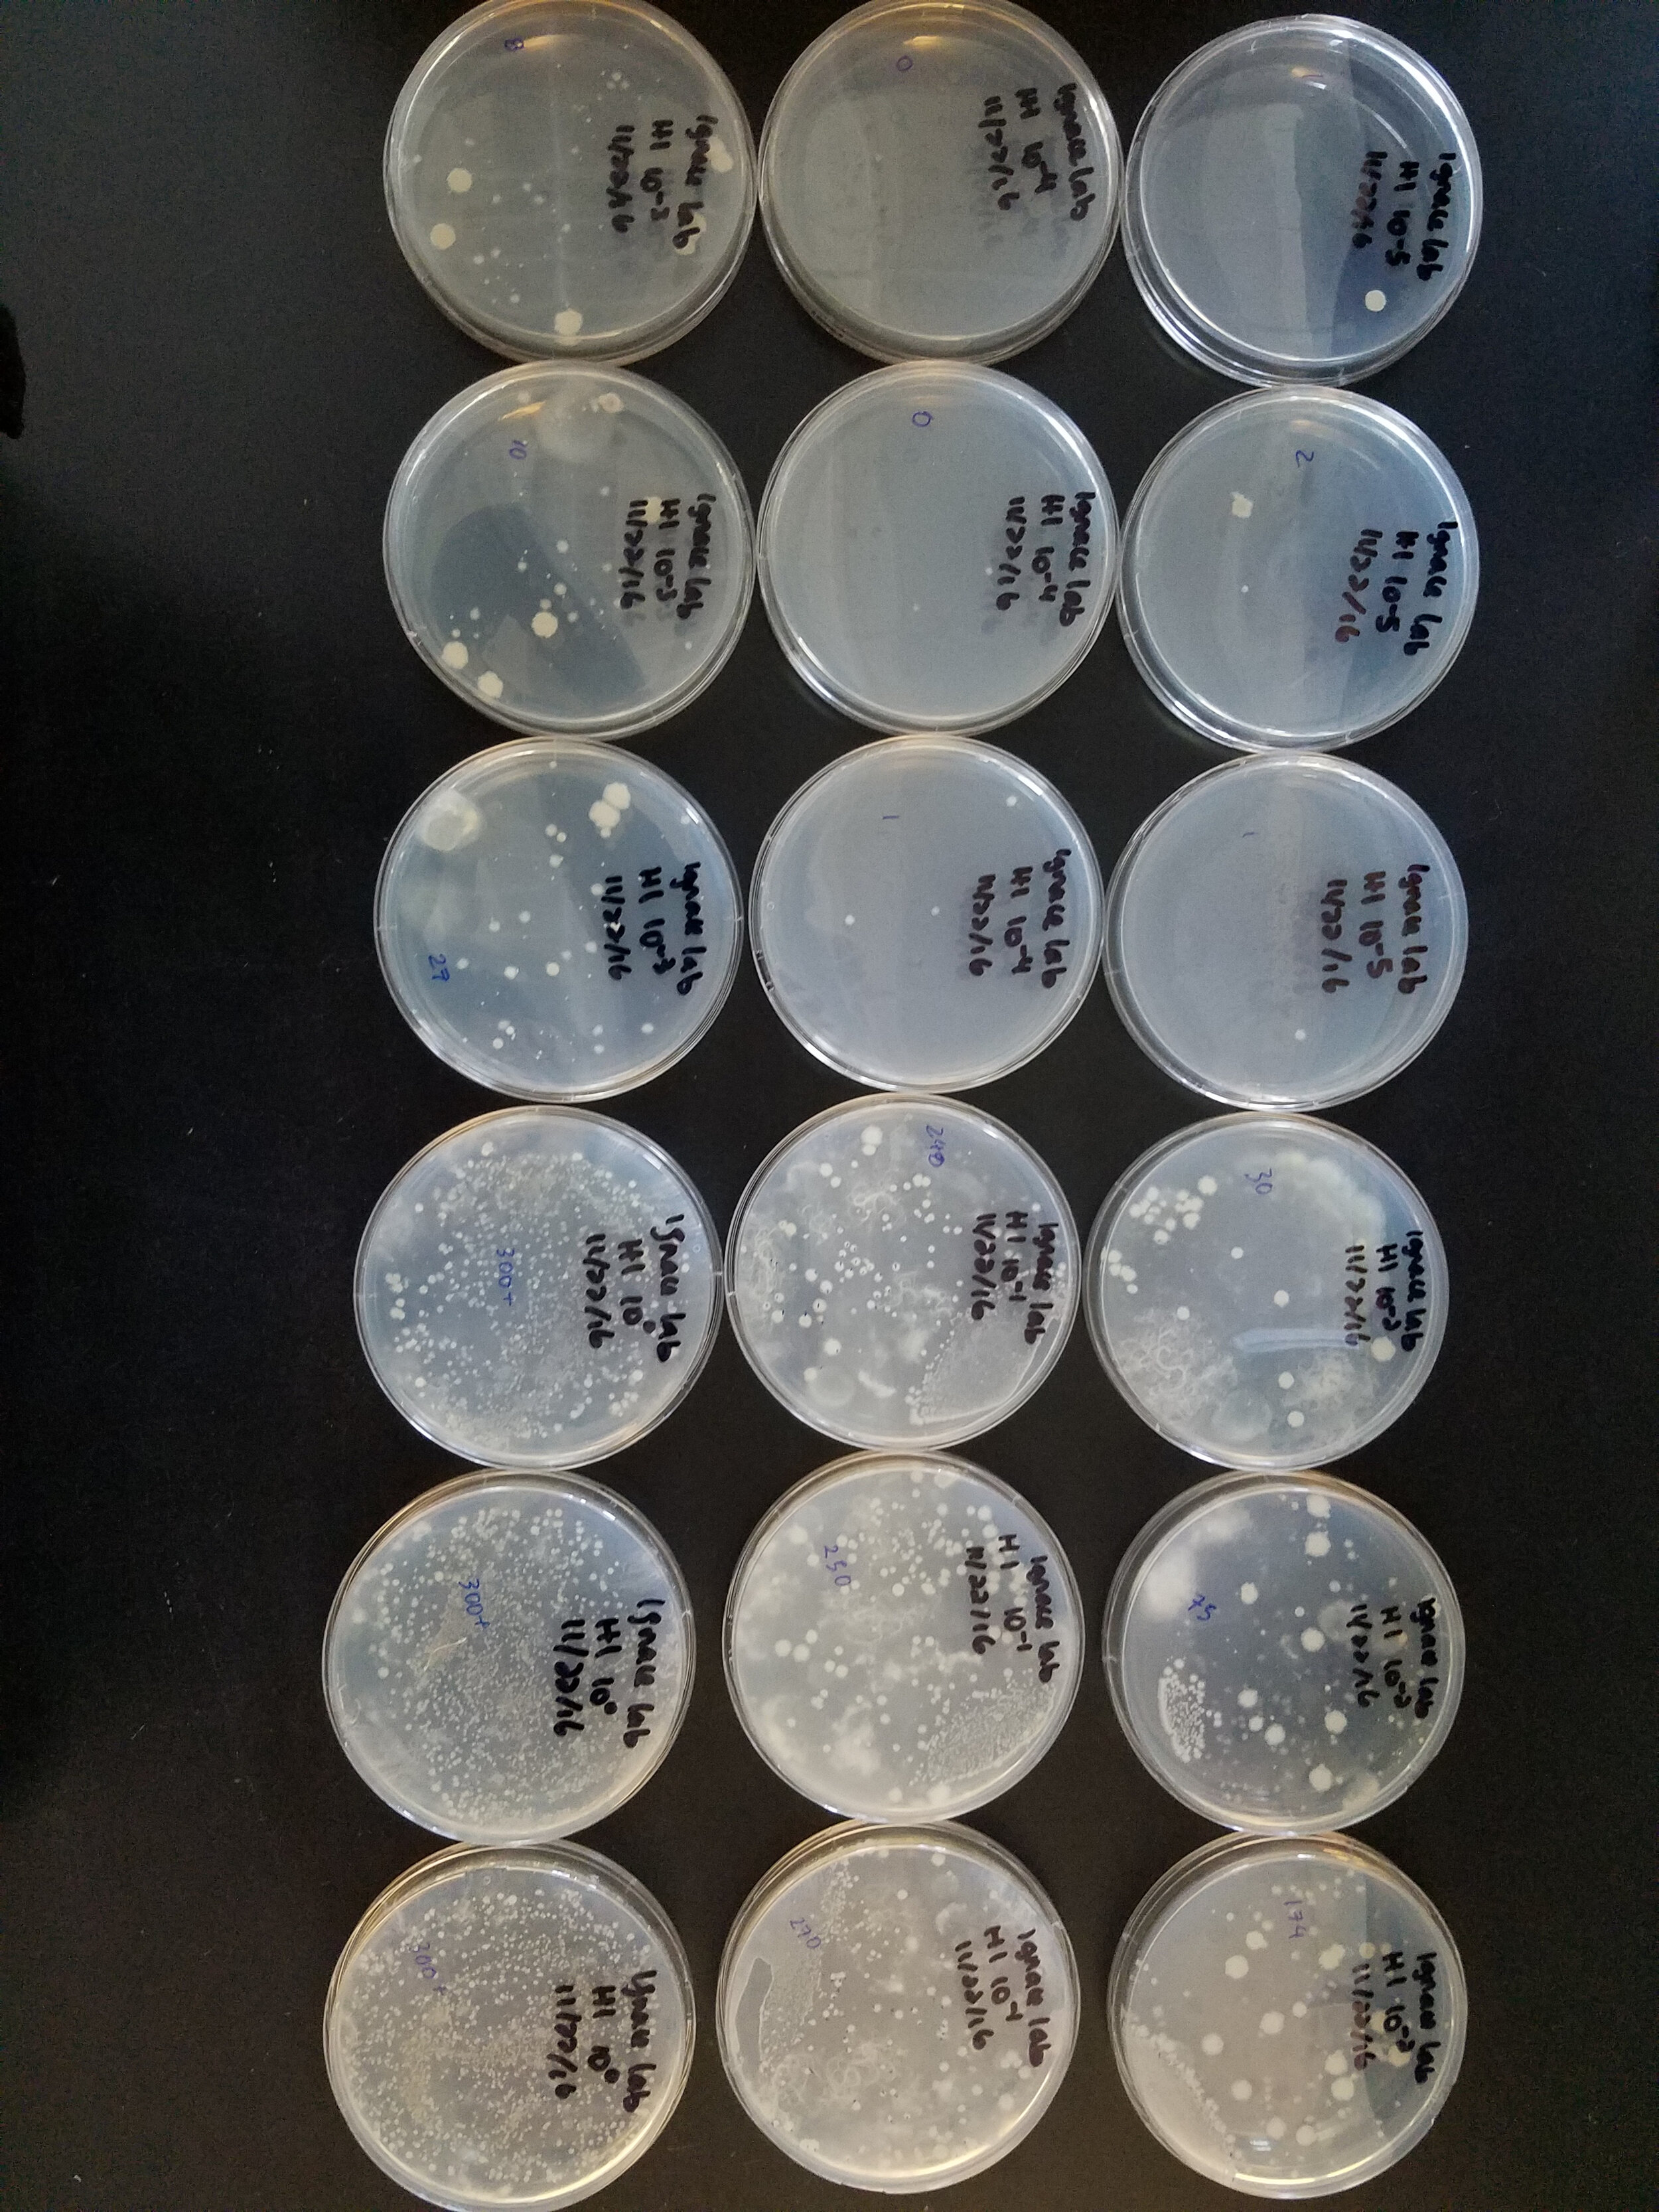
bac.jpg

“Our science is not bound by one type of ecosystem. Our research goal can be applied to all ecosystems.”
Understanding the impacts of global change on ecosystem health and Indigenous communities
How does global change affect ecosystem function and Indigenous communities? As an Indigenous (enrolled member of the Coeur d’Alene tribe) ecophysiologist, I address this question in a wide range of ecosystems, from deserts of southwestern United States to forests in New England and Idaho, and now forests in Canada. The global change factors I investigate include climate change, introduced species (insect pests and plants), and fire (Fig. 1). My research addresses questions that scale from the soil microbial community to ecosystem carbon storage and fluxes, and incorporates the role of species interactions and plant functional traits in ecosystem function. Specifically, my research focuses on several key questions, which interact to affect ecosystem functioning: (1) how do introduced species affect ecosystem carbon storage and nutrient cycling of transitioning ecosystems, (2) how does climate change exacerbate or mitigate the impacts of the introduced species, and (3) what experiments and models can be used to make insightful predictions of these outcomes? I also seek to understand how Indigenous communities are affected by these ecological impacts. Traditional boundary lines do not limit this research program; I deeply believe in forming unique interactions and collaborations with faculty and students to understand and communicate pressing environmental problems.
Figure 1. Global change factors (introduced pests, fire, climate change, and introduced plants) that could positively or negatively affect processes (carbon storage and flux, bacterial and fungal communities, and above- and below-ground nutrient status) for ecosystems in transition. Alterations lead to ecological impacts, which may contribute to climate change and affect the communities that depend on them. (Graphic a collaboration with illustrator Bryant Paul Johnson)
Scroll through below to learn more about the following projects:
1) Implications of declining eastern hemlock (Tsuga canadenis) ecosystems due to the introduced insect pests hemlock woolly adelgid (Adelges tsugae, HWA) and elongate hemlock scale (Fiorinia externa, EHS) AND new work expanding to new sites in Idaho and BC, Canada.
2) New work with the Coeur d’Alene tribe in Northern Idaho
3) Projects at Harvard Forest that amplify Indigenous perspectives & understanding the role of understory species in ecosystem function
4) Understanding the impacts of fire on forest health in Southern Interior BC, Canada
5) An urban project focusing on campus trees, microbes and insects at UBC
6) Environmental justice project based in Houston, Texas
7) Past research in the Sonoran and Chihuahuan Desert
The loss of a foundation species (eastern hemlock) due to invasive pests affects ecosystem function
Hemlock woolly adelgid (Adelges tsugae, HWA) on the left and elongate hemlock scale (Fiorinia externa, EHS) on the right
Eastern US forests are losing a foundation tree species, the eastern hemlock (Tsuga canadenis) due to the invasive insect pests hemlock woolly adelgid (Adelges tsugae, HWA) and elongate hemlock scale (Fiorinia externa, EHS). Eastern hemlock, an evergreen conifer, is a foundation species, as it structures avian communities, ant and benthic invertebrate stream communities, and creates a unique forest floor environment. Destroyed evergreen hemlock forests are typically replaced by the deciduous black birch (Betula lenta) tree species, which can alter ecosystem carbon source/sink dynamics.
An “accidental experiment” was initiated by patch-level timber harvesting of hemlock trees ~30 years ago, which has led to the ideal experimental setup to test for long-term changes in ecosystem function. Destroyed hemlock forests are typically replaced by deciduous tree species, such as black birch (Betula lenta). Several years of data collection from a series of plots in hemlock, young black birch, and mature black birch stands revealed dramatic differences in soil carbon pools and cycling.
Soil respiration (Rsoil, efflux of CO2 from the soil to the atmosphere) represents one of the largest fluxes of the global carbon cycle and reveals carbon source/sink dynamics of ecosystems facing environmental change. I have intensively monitored Rsoil, soil moisture, and soil temperature since 2013 by using a closed-path infra-red gas analyzer system (LI-6400XT; LI-COR Inc.). Additional forest measurements include leaf litter characteristics, soil organic layer depth, and carbon:nitrogen (C:N) content of litter and soil.
Publication #1:
LI-COR 6400XT and Hydrosense measurements
Soil CO2 Flux
Hemlock and young birch stands showed no significant differences in soil respiration rates
Mature birch stands had significantly higher soil respiration rates throughout the entire growing season, regardless of wet or dry years
Soil Moisture
Young birch always maintained higher soil moisture availability throughout the growing season during every year. Mature birch and Hemlock had similar soil moisture due to their high biomass and established forest stands.
Soil Organic Layer Characteristics
The soil organic layer is more massive under hemlock forests than the black birch forests.
hemlock > young black birch > mature black birch
Mature black birch forests use more nitrogen and their soils have less carbon.
C:N of hemlock > C:N of young black birch > C:N of mature black birch
Organic layer depth. Photograph provided by Jesse Bellemare
“Our results suggest that the carbon pool in the forest floor is likely to mobilize through greater decomposition with a 6.8× decline in soil organic layer C storage as hemlocks are replaced by deciduous trees, leading to a potential net release of ~4.5 tons C per hectare.”
Decline of a foundation tree species due to invasive insects will trigger net release of soil organic carbon. Read the full published article in Ecosphere ➔
Publication #2:
Due to the forest floor characteristics that define eastern hemlock forests, the potential to affect fungal and bacterial communities is exceptionally high. Repeated surveys of macrofungi fruiting bodies and assays of bacterial colony-forming units in the soil organic layer were also completed in eastern hemlock- and black birch-dominated plots. Smith College honors student, Aliza Fassler, was first author on a new publication featuring fungi and bacteria in Eastern Hemlock forests. In collaboration with Jesse Bellemare, we found biotic homogenization as Eastern Hemlock trees are replaced by Black Birch trees.
Loss of a foundation species, Eastern Hemlock (Tsuga canadensis), may lead to biotic homogenization of fungal communities and altered bacterial abundance in the forest floor. Read the full published article in Northeastern Naturalist ➔
Publication #3:
Using three years of data, I sought to address how the temperature sensitivities (R10 and Q10) of soil respiration (Rsoil) vary and found that determinants of Q10 and R10 differed between forest type, with soil moisture primarily influencing Q10 in hemlock and mature birch stands and soil temperature primarily influencing R10 in mature birch stands. These results suggest a complex interaction of soil moisture and soil temperature, and potentially substrate quality and quantity, as determinants of temperature sensitivities. (Ignace 2019 PLoS ONE).
Determinants of temperature sensitivity of soil respiration with the decline of a foundation species. Read the full published article in PLoS ONE ➔
As Hemlock forests transition to Black Birch forests:
Graphic is a collaboration with illustrator and graphic designer Bryant Paul Johnson. See the Art-Science Collective for more information about this collaboration and other science communication projects.
Taken together, this multi-year research effort has shown the following impacts as eastern hemlock forests transition to black birch forests: (1) growing season soil CO2 flux increases, (2) the soil organic layer mass is reduced, (3) C:N of leaf litter and soil is reduced, (4) there is a 6.8x decline in soil organic layer C storage with a net release of ~4.5 tons C per hectare, (5) macrofungal communities become homogenized, (6) peak bacterial abundance shifts to the fall, and (7) these differences may be exacerbated by future climate warming.
Future Directions:
Adding more sites to understand the widespread impacts of these pests on eastern hemlocks
Expanding this work to western hemlocks in the Pacific Northwest (I’m looking for collaborators!)
Using drones to detect tree health
In collaboration with Jon Caris from the Spatial Analysis Lab and Jesse Bellemare, our goal is to quantify ecosystem carbon dynamics in northeastern US forests that are declining due to the infestation of non-native pests and its consequences for climate change. By integrating stationary gas analyzers, portable gas analyzers fitted with unmanned vehicles, and advanced imaging systems, we seek to develop novel methods and models that are cost-effective and efficient.
This project was initiated by a collaboration with Environmental Science & Policy major, Steph Long. The purpose of this project was to create a model for determining the health and detecting dieback of eastern hemlock trees using drone imagery and spatial analysis software. Stay tuned for updates!
For more information about this process watch our video!
Building climate resilience in forests on the Coeur d’Alene Reservation
As my tribe (Coeur d’Alene) seeks to reduce timber cuts of forests and move towards regenerating forest health, we have yet to develop an enhanced forest management plan that aims to build resilience in the face of global change. We seek to identify missing values and Indigenous Knowledge within our current forest management framework to build climate resilience for our community. This will involve a systematic analysis of values or management goals within our current forest management plan and developing a framework and assessment tool that will highlight opportunities to elevate Indigenous Knowledge in adaptation management. Please reach out to hear more details about this exciting new work!
Research Projects at Harvard Forest
I have been deeply involved with collaborative research projects and the Research Experience for Undergraduates (REU) summer program at Harvard Forest (HF) since 2013.
Current collaboration: Amplifying Indigenous voices at Harvard Forest
Pictures with Meg Graham MacLean 2022 REU students (Santiago Alvarado & Rachel Carethers), Nia Holley (Nipmuc), and Clarisse Hart
Overview:
Current and historical records of land use and land stewardship in New England too often exclude the voices and knowledge of Indigenous People, Black People, and People of Color. For over a century, the Harvard Forest has pursued its mission of research & education on 4,000 acres of unceded Nipmuc homeland. Today we are working to build a long-term relationship with the Nipmuc People that ensures that this land and its life-giving benefits are accessible, affirming, and sustaining, and remain so for generations to come. Amplifying Indigenous voices in land stewardship and ecology has never been more vital as the world faces the dramatic impacts of global change primarily induced by extractive colonialism. Thus, it is a defining time to diversify perspectives and voices in the forestry and land use paradigm.
Over the past two years, we have begun to develop a reciprocal, respectful, and perpetual relationship with the Nipmuc tribe by focusing on transparency and co-establishment of a collaborative path forward. We began with a collaboration to re-imagine the land narrative in our on-site museum. We then established a (paid) framework for collaborative mentorship of student interns on projects that support tribal land management. In summer 2022, Harvard Forest students conducted a field experiment on the relationships between culturally important plants and an invasive species, Rosa multiflora, to inform management of newly acquired tribal land.
The goals of our 2023 project are twofold:
1) Build on a pilot land stewardship study initiated with the Nipmuc community during the 2022 HF Summer Program, focused on relationships of culturally important species, invasive species, and fire.
2) Collect and analyze existing Indigenous forest stewardship plans in the Eastern Woodlands and elsewhere to contribute knowledge to stewardship plans for newly rematriated Nipmuc forest land in the region.
These two projects are highly complementary, giving students the opportunity to apply an interdisciplinary approach in this group collaboration. Students will be encouraged to work with their mentors to carve out pieces of this project that align most with their interests.
To learn more about the Harvard Forest 2023 REU Summer Program, click here.
In 2021, I led the first project focusing on Indigenous perspectives and diversifying the library at Harvard Forest for the 2021 virtual REU Summer Program. With co-leaders (Meghan Graham MacLean and Marissa Weiss) we mentored two students (Rafa Viana Furer & Lehua Blalock) on this exciting project that has never been done before at Harvard Forest. Students interviewed Indigenous scientists and land stewards with plans on creating a website to provide the information using creative translation of the narratives.
In 2022, we followed up on our 2021 work with two new REU students (Santiago Alvarado & Rachel Carethers) to start a pilot project understanding the relationships with invasive plants and culturally important species. Co-leaders on this projects include Nia Holley (Nipmuc), Meghan Graham MacLean, and Clarisse Hart). It is important to protect culturally important information, thus species information and findings will be released at a later date.
Past collaborations at HF: All about leaf level gas exchange
In 2019, I collaborated with Dr. Sydne Record, Dr. Jackie Matthes, Fiona Jevon, and Paige Kouba. The goal of this project is to understand the role of seedlings in the theory of energy equivalence and the Janzen-Connell hypothesis. Seedling energy flux was measured on dominant seedling species including red maple, red oak, white pine, and eastern hemlock. Data from environmental response curves (CO2 and light) provide a full suite of the physiological and biochemical limitations to photosynthesis for an individual plant in order to inform more accurate models. This summer was a particularly productive season and we expect several manuscripts to be produced this year.
A more detailed summary of sub-projects and references can be found on the Harvard Forest website ➔
During the summer of 2013, I collaborated with Dr. Audrey Barker Plotkin, Dr. Liza Nicoll, Dr. Jim Tang, and Dr. Joshua Rapp and evaluated the physiological traits of important understory species, as they are contributors to ecosystem level productivity. During the summer of 2014, I collaborated with Dr. Christopher Williams at Clark University and I evaluated how dominant species contribute to the development and productivity of forests that are rebounding from clearcutting. Results showed tremendous increases in the productivity of several dominant species over time and were strongly dependent on climate, soil nutrient levels, and physiological function. Both summers led to an important REU for Smith College students, two of which are co-authors on a manuscript that is currently in preparation.
Impacts of fire in Southern Interior British Columbia
In collaboration with Dr. Lori Daniels (UBC), we are studying the role of fire for management for plant communities and forest ecosystem health. This research aims to build the ecological foundation for renewed cultural fire and prescribed burning in West Vaseux Lake, near Okanagan Falls (interior BC). My research group completed a large survey of soils and vegetation (plant composition) health across the fire treatment plots at this study site. This year, the lab will be completing work to gain information on the bacterial and fungal diversity across fire treatments. Miah Godek (PhD), Gracie Crafts (MSc), and Tatyana Schneider (undergrad) completed YEAR 1 of their work in summer 2023. Please reach out to hear more details of this ongoing work.
Campus Tress, Microbes and Insects (CTMAIN)
In collaboration with Dr. Michelle Tseng (Botany), Dr. Warren Cardinal-McTeague (Forest and Conservation Sciences), Dr. Richard Hamelin (Forest and Conservation Sciences), and Tara Moreau (UBC Botanical Garden), we seek to build database for understanding how tree traits mitigate climate change and enhance biodiversity on the UBC campus. Our goals are multifold. In 2023-2024 we will (a) mentor a new graduate student (Devlin Grewal) working on the project, (b) select 20 sites to prototype the development of our enhanced tree trait and community database, (c) develop genomic methods to identify microbe and insect communities; and (d) expand the current tree database to include data that provides comprehensive information about tree traits over their lifespan. Please reach out to hear more details about this new work that just started!
Environmental Justice Projects
I was selected as a Science for Social Equity Fellow (2021-2023) to work with a community engager on creating community-driven solutions to climate change. In partnership with community engager, Briana Brown, we are working with neighborhoods in Houston to include their voices in the pursuit of becoming resilient to climate change and pollution. The Science for Social Equity initiative is a special project of Fair Count, Inc. Click here to read more! The outcomes of this project will be presented at the 2021 SACNAS conference.
There is a need for members of Black & Brown communities in the 5th & 3rd Wards of Houston, TX to be involved, access resources, and provide feedback on programs and policies regarding climate change and air pollution, considering that these communities are most impacted and least consulted or are least contributing to the problem. Our goal is to collaborate with Houston-based organizations to share and collect data about the problem and empower community members to be advocates for actionable change.
So far, we’ve formed partnerships with local experts and organizations and engaged with community members through various events and platforms.
We created a toolkit that visualizes the impacts of climate change and environmental hazards on the local community along with contact information and ways to contribute to the dialogue. Stay tuned for events coming up in 2023!
Desert Research #1: Community change in the Chihuahuan Desert (southern Arizona)
Our field site near Portal, AZ.
Foundation work (my postdoc years with Peter Chesson):
I have been working on a Chihuahuan Desert ecosystem since 2007. This research focuses on understanding the mechanisms and impacts of a non-native plant species. A non-native Eurasian winter annual plant species, Erodium cicutarium, has been implicated in driving down the native biodiversity and abundance in Arizona and many parts of the U.S. However, a native plant, Astragalus nuttallianus, has also increased its abundance in recent years. Removing Erodium cicutarium actually decreased the abundance of native species, except for Astragalus nuttallianus. These two species co-dominate this system, with the potential for facilitative interactions.
Read the full published article in Ecology ➔
My multi-year large-scale field and lab experiments investigating the role of climate change and pollution (nitrogen deposition) in the invasion have been very successful and have yet to be published.
Surprisingly, climate change was not found to be the main driver of invasion success nor community change over time.
Seasonal climate characteristics determined years with guild success.
Read the full published article in Evolutionary Ecology Research ➔
A full-factorial experiment with invasive removal, water timing, and nutrient levels.
Students applying nutrient treatments
Recent Projects:
The lab has worked on plant competition experiments to investigate the relationship between Erodium cicutarium and Astragalus nuttallianus. Different combinations of these species are being exposed to two temperature and two water treatments in our growth chambers.
Desert Research #2: Functional responses of Sonoran Desert plant species to precipitation (southern Arizona)
Come back soon for a summary on my doctoral work with Travis Huxman